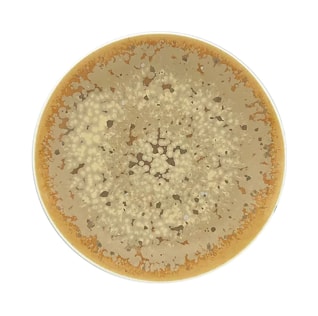
Jaune de Chrome, Song Ocre, Bread and butter plate
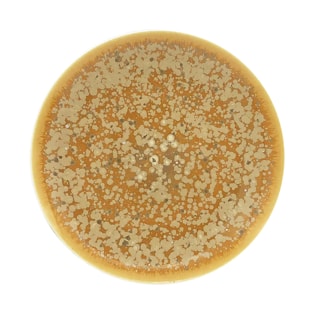
Jaune de Chrome, Song Ocre, Dessert plate

Song Ocre
Ocre colors in Juane de Chrome's Song dinnerware collection bring a feel of everlasting elegance, with quiet mineral-like touches that make them more beautiful. This special choice of color gives warmth and depth, making your eating area a place of sophisticated beauty. No matter if you are having a simple morning meal or a big dinner event Song Ocre china collection makes the eating time better, adding a stylish sense that fits with both new tastes and old beauty.
Made with amazing enamel skill Song Ocre dinnerware collection by Jaune de Chrome will catch your attention with its special design, making every item unique. Soft and with a feel of minerals, this set of dishes comes in shades of Ochre for a fancy and shiny table setup.
Other Jaune de Chrome collections
Jaune de Chrome
Song Ocean
The Song Ocean dinnerware collection by Jaune de Chrome brings to life the calm allure of a sea breeze. This...
Jaune de Chrome
Bolero Blue
Indulge in the allure of exquisite fine china with Jaune de Chrome's Bolero Blue dinnerware collection. Jaune de...
Jaune de Chrome
Song Amande
Savor the revitalizing aura of a gentle zephyr with Jaune de Chrome's Song Amande dinnerware collection...
Jaune de Chrome
Song Perle
Song Perle, a luxurious collection by Jaune de Chrome, showcases the artistry and expertise that have made the brand...
Our top brands